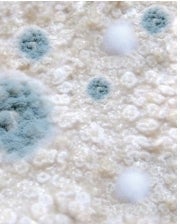

本ページを見て頂きありがとうございます。
株式会社シートデバイス開発 代表取締役 嶺川敦彦です。長年寺社仏閣の
修復金具や錺金物を永く保護するためのコーティング加工を営んでおります。
漆や金箔の表面を数十年守り続けるものです。

ある時、お寺のご住職からのご相談事で、檀家さんが
ペットのご遺骨を大切に保管していたはずが、
カビや悪臭が出て大変な事になってしまったとの事でした。
 市販のペット用骨壷
市販のペット用骨壷
カビ発生
カビ発生
ペットの葬儀は、お寺さんや専門業者があり各種サービスもあります。
手元供養とは、家族の一員だったペットのご遺骨を自宅など身近に置いて供養する
方法で納骨せずに持ち帰るご遺族が多いと聞いております。
悲しみを和らげ、身近に感じられ偲ぶことが出来ます。
しかし、持ち帰った後のご遺骨のことは誰も教えてくれません。
持ち帰る場合、ペットのご遺骨は、骨壷に収められており
自然の湿度に大変弱く、劣化が侵攻していきます。
骨の主成分はリン酸カルシウムと炭素ですが、このリン酸カルシウムが
骨壺内の水分と反応することで、ゆっくりと分解され、最終的に跡形もなく
消えてしまいます。
骨壷に、雑菌やカビ菌が入り込むと劣化のスピードが早くなるだけではなく
悪臭の原因ともなります。
安置されている環境にもよりますが、6ヶ月間~数年間で劣化が侵攻します。
骨壷内を見ても雑菌やカビ菌の侵攻は目に見えない事が多く
乾燥剤や除湿剤も、多少侵攻時間を伸ばすだけです。
また、骨壷の破損やお掃除の時に倒したりすることも心配です。
持ち運びが難しく、ペットと一緒に行っていた、思い出の場所や旅行などに
持っていけません
また、地震や災害時などで骨壷が破損したり、濡れることもあります
大切に保管していたはずが、カビや悪臭が出て大変な事にならいように
ずっと一緒に寄り添える手元供養の弊社オリジナル商品 Remember Me(リメンバー・ミー)が出来ました。
Remember Me(リメンバー・ミー)が出来ました。
特殊樹脂を使って一つひとつ丁寧に本体を成形します。
着色などは、寺社仏閣で使用する古来製法の顔料や
金属粉の耐久性のある顔料です。
更に、お預かりするご遺骨を丁寧に洗浄・パウダー化
(粉骨処理)特殊樹脂に練込みます。
ご遺骨を練込んだ特殊樹脂は、表面を高貴な金属粉顔料に包まれて、
本体内部に密封します。外側からご遺骨は見えません。
(底部からのみご遺骨を確認することが出来ます)
全体の強度アップのために保護用ガラスコートを施します。
ご遺骨が空気に触れることが無く、耐水性があり、紫外線対策も万全です。
数十年間安心して、ずっと一緒に寄り添える手元供養が出来ます。

資金の使い道
ご支援やご注文頂いた資金は、ご遺骨の管理費や
リターン商品の製作費などに使わせて頂きます。
スケジュール
・11月 初旬 クラウドファンディング終了
・11月 中旬~ 確認・受付 順次商品製作
・12月 順次お届け
ご注文の流れ

リターンについて
・早期購入 チューリップ(各色) +台座付き:¥30,000(税込)
・早期購入 ダイヤモンド(各色) +台座付き:¥20,000(税込)
・早期購入 水玉(各色) +巾着付き:¥15,000(税込)
・応援¥2,000 :お礼のメール+割引券 10%OFF
(12月からの弊社商品のネット販売でご支援様のみ ご利用頂けます)
有効期限:2024年12月31日
・応援¥5,000 :お礼のメール+割引券 20%OFF
(12月からの弊社商品のネット販売でご支援様のみ ご利用頂けます)
有効期限:2024年12月31日
最後に
家族の一員だったペットにずっと寄り添い手元供養を
清潔・安心に行える可愛らしい商品になっております。
大切な家族を失った悲しみの中に、少しでも不安が解消し
元気になって頂けたら幸いです。
FAQ
問:残った遺骨はどうしたら良いのでしょうか?
提案:思い出の場所に散骨されたらいかがでしょうか
(各自治体で散骨のルールがあります)
別途連絡を頂ければ、弊社にてパウダー化(粉骨処理)を行い
お返しすることが出来ます。(ご遺骨の量によりお見積をいたします)
問:ご遺骨を専用袋に10g程度とは、どれくらいの量ですか?
回答:1円玉で10枚、10円玉で2枚ぐらいの重さです
弊社でパウダー化(粉骨処理)を行いますので商品に使わなかった
粉骨は、商品と一緒に返骨します。
問:粉骨した遺骨を持っているのですが価格は一緒ですか?
回答:はい、一緒です。
弊社で再度洗浄します。(雑菌やカビ菌対策です)
更に、今回早期価格となっておりますので同一価格です。
問:遺骨が無くなったり、混ざったりしないのですか?
回答:お預かりしたご遺骨は、全て手作りで管理番号を付け
一つひとつの工程を経て、製作しています。
無くなったり、混ざったりすることはありません。
問:白っぽい遺骨をパウダー化すると色が変わりますか?
回答:はい、少し茶色っぽく見えます。
特殊樹脂で密封するため、ご遺骨本来の色目となります
ペットの種類や火葬状態でも変わります。
<募集方式について>
本プロジェクトはAll-in方式で実施します。目標金額に満たない場合も、計画を実行し、リターンをお届けします。
最新の活動報告
もっと見る
Webショップで販売開始しました。
2023/11/20 16:33この度、各種お問合せが多くありましたので、Webショップにて販売を開始しました。 https://store.shopping.yahoo.co.jp/mercy-forever/ もっと見る












コメント
もっと見る